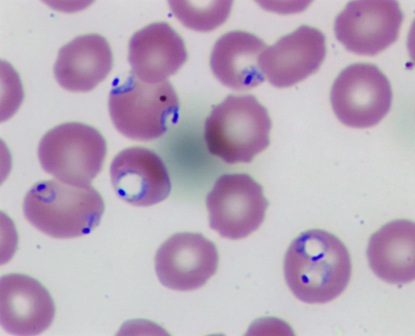
FIGURE.

A 22-year-old woman with no past medical problems was admitted with extreme fatigue, headache, fever, decreased appetite, and jaundice 2 days after returning from a 3-month mission trip to Ghana. She reported many insect bites in Africa and may have been bitten by a spider before becoming ill. She had sought no pretravel counseling before venturing to Ghana and was prescribed chloroquine for malaria prophylaxis when she arrived in Ghana. One month after being in Africa, she had intermittent fever, headache, and fatigue. Findings on evaluation in Ghana for malaria and typhoid were unremarkable.
The patient was taking no other medications and had no relevant family history. She denied blood transfusions, injections, sexual exposures, animal exposure, alcohol use, illicit drug use, or contact with ill persons in Ghana. She drank bottled water and ate cooked food and freshly peeled fruit. In addition, she denied swimming in lakes or rivers while there.
On admission, the patient appeared ill. She was normotensive (blood pressure, 114/69 mm Hg), tachycardic (heart rate, 125 beats/min), afebrile (temperature, 37.2ΥC), and tachypneic (respiratory rate, 20 breaths/min) with an oxygen saturation of 96%. She was noticeably jaundiced and somnolent. Hepatosplenomegaly was present on examination. Skin examination revealed two 1-cm black eschars on her left lateral thigh.
1. Which one of the following would not be included in the initial differential diagnosis of this patient's jaundice?
Viral hepatitis
Malaria
Dengue fever
Acute cholangitis
Yellow fever
The potential causes of fever and jaundice in a returning traveler are many. Acute viral hepatitis, particularly hepatitis A and B, would be a possibility in this patient's case. In symptomatic patients, the illness begins with the abrupt onset of symptoms including fatigue, malaise, nausea, vomiting, anorexia, fever, and right upper quadrant pain. The 2 most common physical examination findings are jaundice and hepatomegaly, as were noted in this patient's case.1 Her pretravel vaccination status is unknown, and therefore hepatitis remains a possibility.
Malaria, caused by 4 Plasmodia species and spread predominantly by the bite of a female Anopheles mosquito, affects 500 million people a year, mainly in developing nations.2 The parasite causes intracellular hemolysis, leading to fever and jaundice, as well as hepatosplenomegaly, headache, myalgias, fatigue, and nausea.
The dengue virus complex, the vector of which is a diurnal mosquito of the genus Aedes, causes more than 100 million infections globally per year.3 It presents as an acute febrile illness usually lasting about 1 week. Other symptoms include persistent fatigue, myalgias, arthralgias, and rash. A small subset of patients can present with dengue hemorrhagic fever. Although dengue fever is prevalent in Africa, its incidence is lower there than in Southeast Asia or the Caribbean.
The classic presenting symptoms of acute cholangitis are fever, right upper quadrant pain, and jaundice. It is generally caused by a blockage in the biliary tree, leading to biliary stasis and infection. The prolonged nature of our patient's symptoms makes this diagnosis unlikely.
Yellow fever is a mosquito-borne viral illness occurring in tropical areas of South America and sub-Saharan Africa. Hallmarks of severe illness include fever, jaundice, renal failure, malaise, and headache. Symptoms typically occur within 7 days after the bite by the infected mosquito. A live virus vaccination has been available for decades. Routine vaccination of military personnel and travelers has decreased the incidence of yellow fever.
Initial laboratory studies yielded the following results (reference ranges provided parenthetically): hemoglobin, 7.9 g/dL (12.0-15.5 g/dL); white blood cell count, 7.3 × 109/L (3.5-10.5 × 109/L); platelet count, 8 × 109/L (150-450 × 109/L); lactate dehydrogenase, 1342 U/L (122-222 U/L); haptoglobin, less than 14 mg/dL (30-200 mg/dL); international normalized ratio, 1.1; activated partial thromboplastin time, 36 seconds (21-33 seconds); and a peripheral smear showing thrombocytopenia without schistocytes. A transaminitis was noted with an aspartate aminotransferase level of 124 U/L (8-43 U/L) and an alanine aminotransferase level of 84 U/L (7-45 U/L). The level of indirect bilirubin was 14 mg/dL (0.1-1.0 mg/dL), and the level of direct bilirubin was elevated at 10 mg/dL (0.0-0.3 mg/dL). The creatinine level was 1.1 mg/dL (0.6-1.1 mg/dL); the bicarbonate level, 15 mEq/L (22-29 mEq/L); the anion gap, 16; and glucose, 60 mg/dL (70-100 mg/dL). Urinalysis was notable for bilirubinuria.
2. Which one of the following diagnostic tests would be the most appropriate next step in the evaluation of this patient?
Abdominal ultrasonography
Viral hepatitis serologies
Malaria smear
Coombs test
Bone marrow biopsy
The initial laboratory data suggest an underlying hemolytic anemia process, with associated thrombocytopenia and a mild transaminitis. Abdominal ultrasonography may define the degree of hepatosplenomegaly and could identify any biliary ductal dilatation. However, gallbladder and primary liver disease were not thought to be the primary problem in this patient, and thus abdominal ultrasonography would not be the first test to consider.
As already mentioned, acute hepatitides would be a concern in a returning traveler with jaundice and hepatomegaly. Concern for acute hepatitis should generally prompt viral hepatitis serologies. However, the transaminase elevation in acute hepatitis is generally in the thousands to tens of thousands range, which is not the case with this patient. Therefore, viral hepatitis serologies would not be the next appropriate study.
Patients returning from areas of the world where malaria is prevalent should be tested urgently for malaria with a thick and thin smear. If clinical suspicion is high and findings on the first thick and thin smear are negative, then smears should be repeated every 8 to 12 hours for 48 hours.4
Given the presence of hemolytic anemia and thrombocytopenia, one might consider a full hematologic work-up with a Coombs test and/or bone marrow biopsy. Positive findings on a direct Coombs test would suggest an autoimmune hemolytic anemia. If a primary bone marrow disorder is strongly suspected, a bone marrow biopsy should be considered. However, in a traveler returning from Africa with fever, jaundice, and hemolytic anemia, neither autoimmune hemolytic anemia nor primary bone marrow disorders are major concerns. Thus, these tests would not be the next best steps.
A malaria smear was performed on admission and was positive for the presence of an intracellular parasite in 22% of the patient's red blood cells with no enlargement of the red blood cell size.
3. Which one of the following is the most likely diagnosis in this patient?
Human babesiosis
Plasmodium malariae malaria
Plasmodium vivax malaria
Plasmodium ovale malaria
Plasmodium falciparum malaria
Babesiosis, a tick-borne illness caused by an intracellular protozoon, leads to hemolytic anemia. It is transmitted to humans via the tick vector Ixodes scapularis. In the United States, it is reported along the eastern seaboard and the upper Midwest. However, human babesiosis is extraordinarily rare in Africa. Because the patient's illness developed in Africa and because she had no risk factors for severe Babesia sp infections, human babesiosis is unlikely.
Plasmodium malariae, P vivax, and P ovale are causes of malaria in varying geographic locations worldwide. Infections from these parasites cause hemolytic anemia and fever; however, in general, parasite burden is low and acute life-threatening illnesses are rare.
Plasmodium falciparum malaria is found in the tropics. The parasite invades red blood cells of people of all ages, causing high levels of parasitemia (Figure). In contrast to the enlarged red blood cells in patients infected with P vivax and P ovale, the size of the red blood cells in patients infected with P falciparum remains unchanged. In a nonimmune person such as our patient, P falciparum malaria can cause life-threatening disease if not treated. Most deaths due to severe malaria occur within the first 24 to 48 hours of presentation. This is a medical emergency and requires prompt diagnosis and initiation of appropriate therapy. Because P falciparum malaria is very common in sub-Saharan Africa and given the degree of illness on presentation, P falciparum malaria is the likely cause of this patient's symptoms. It is the most common cause of fever in travelers returning from Africa.
FIGURE.
A photomicrograph of a Giemsa-stained thin smear showing red blood cells with multiple ring stages of Plasmodium falciparum.
On microscopy of the smears, P falciparum was identified, with 22% of the red blood cells infected. Prompt antimalarial therapy was begun with intravenous quinidine gluconate and doxycycline. Because of the severity of the patient's disease and high parasitemia, exchange transfusion was commenced.
Malaria smears were monitored during the patient's hospital stay and were negative by day 4 of hospitalization. However, during her hospitalization, the patient developed mental status changes, worsening hypoxia and bilateral pulmonary infiltrates, nonoliguric renal failure, hypoglycemia requiring intravenous dextrose replacement, and prolonged QT interval (660 ms). She was intubated, mechanically ventilated, and given continuous renal replacement therapy.
4. On the basis of the clinical diagnosis, which one of the following complications is not associated with the disease process?
Seizure
Acute kidney injury
Hypoglycemia
Acute respiratory distress syndrome
Cirrhosis
Cerebral malaria presenting with seizures and altered mentation is a common finding in up to one-half of patients with P falciparum malaria. This finding is more common in children, immunodeficient patients, and adults with no malaria immunity. Cerebral malaria is universally fatal if not treated promptly, and 20% of adults who receive adequate treatment still die.5
Acute kidney injury, which is fairly common in patients with P falciparum malaria, has various causes, including hypovolemia, disseminated intravascular coagulopathy, ischemia from parasitized red blood cells, and hemolysis.6
Hypoglycemia, a common complication of the primary disease, is related to increased glucose uptake by the parasite and decreased glycogen stores from anorexia. In addition, treatment with quinine causes a hyperinsulinemic effect, further driving the blood sugar down.7
Acute respiratory distress syndrome or pulmonary edema is another common complication of P falciparum malaria and its treatment. Two potential causes of acute respiratory distress syndrome are pulmonary capillary leak and sequestration of parasitized red blood cells in the pulmonary alveoli.5 Volume overload also frequently occurs with resuscitation of the patient.7
Transaminase elevation is a very common finding in malaria. Malarial hepatitis, a fairly common complication in hospitalized patients with P falciparum malaria, is associated with a worse outcome.8 Many of the medications used to treat P falciparum malaria are also associated with transaminase elevations. However, neither chronic hepatitis nor cirrhosis is associated with malaria infections.
The patient had a prolonged hospital course because of numerous malaria-related complications; she was discharged after 35 days. As of the writing of this article, she has had no further sequelae from her infection.
5. Which one of the following pretravel recommendations should not be made for a trip to West Africa?
Wearing of protective clothing to cover exposed skin to prevent mosquito bites
Application of insect repellents containing DEET (N, N-diethyl-m-toluamide) on skin
Sleeping in bed nets, preferably soaked in permethrin
Malaria chemoprophylaxis with chloroquine
Malaria chemoprophylaxis with doxycycline, atovaquone-proguanil (Malarone), or mefloquine
Malaria is a preventable disease among travelers if particular precautions are taken. Because the Anopheles mosquito feeds between dusk and dawn, taking proper precautions at this time of day is important. Wearing clothing to cover exposed skin, application of insect repellent containing DEET in concentrations of 20% to 50%, and sleeping in mosquito-proof tents or homes and using bed nets with or without permethrin (an insecticide) all will reduce the risk of contracting malaria.9
In addition, taking the proper chemoprophylaxis for the proper duration is imperative. In sub-Saharan Africa, chloroquine-resistant P falciparum malaria is common. Therefore, chloroquine would not be an appropriate chemoprophylaxis. However, chemoprophylaxis with atovaquone-proguanil (Malarone), mefloquine, or doxycycline would be an effective option.9
DISCUSSION
Malaria is one of the leading causes of infectious disease morbidity and mortality worldwide annually. Endemic in the southeastern United States through the 1940s, malaria remains widespread in areas where nearly one-half of the world's population lives. The greatest risk of malaria transmission is in Oceania, sub-Saharan Africa, and the Indian subcontinent.2 Four species of Plasmodium (P falciparum, P vivax, P ovale, and P malariae) cause disease in humans. Of these, P falciparum infections contribute to most of the deaths.
Malaria is transmitted predominantly via the bite of female Anopheles mosquitos, which generally feed between dusk and dawn. However, malaria can also be transmitted via blood transfusion or organ transplant and through the placenta.2 The pathogenesis and life cycle of the parasite is well described in the medical literature. Ultimately, the parasite matures in the host's red blood cells, altering their shape and attachment characteristics. They become less deformable, leading to obstruction of small arterioles and hemolysis.
The incubation period varies depending on the species of Plasmodium and use of chemoprophylaxis. Typically, for P falciparum, P vivax, and P ovale, symptoms begin about 2 weeks after mosquito bite in those not taking chemoprophylaxis and may take longer to appear in those who are. The incubation period for P malariae can be longer, ranging from 18 days to several months.7 P falciparum infections in travelers often present within 3 months after return, whereas P vivax infections often present 3 or more months after return. The presenting symptoms are varied, but nearly all those infected experience fever. The fever spikes develop with the release of the parasite from the infected red blood cells. Other common findings include headache, myalgias, fatigue, jaundice, anemia, thrombocytopenia, and hepatosplenomegaly.
The gold standard for diagnosis is light microscopy of Giemsa-stained thick and thin smears. The first smear is positive for malarial parasites in 95% of cases; however, if the smear is negative and malaria is still suspected, repeating the smear every 12 hours for 48 hours is prudent.4 The thick smear is more sensitive for diagnosing malaria, whereas the thin smear is done for species identification and quantification of parasite burden. Other diagnostic modalities, including fluorescent microscopy and polymerase chain reaction-based testing, are available but not routinely used.7
Treatment of malaria depends on the species of Plasmodium and the degree of illness. Severe malaria—defined as a parasite load greater than 5%, end organ damage, severe anemia, or hypoglycemia—requires parenteral therapy with quinidine plus tetracycline, doxycycline, or clindamycin in the United States.7,10 Artemisinin-based combination therapies are more effective and are the World Health Organization's recommended treatment worldwide. As of June 2007, intravenous artesunate (to be used in combination with a second antimalarial agent) is available in the United States through the Centers for Disease Control and Prevention (CDC) for treatment of severe malaria; the treatment algorithm was outlined in a 2007 review article.7
Exchange transfusion, used in this case, is not considered standard therapy. The use of exchange transfusion shows benefit in the rapid removal of parasites and antigens from the blood; however, no adequately powered studies have ever been performed of its efficacy, making its use controversial. The CDC recommends its use in patients with parasitemia over 10% or in the presence of such complications as cerebral malaria or acute kidney injury.7
Patients with severe disease need intensive care monitoring. Potential complications include pulmonary edema, acute kidney injury, seizures, coma, hypoglycemia, and severe anemia and thrombocytopenia. Hypoglycemia is not uncommon and needs to be closely monitored and actively treated.
The most effective way to prevent malaria in travelers is through pretravel education, use of insect repellents, and appropriate chemoprophylaxis. Chloroquine is preferred in the Caribbean and Central America, where chloroquine-susceptible P falciparum is prevalent. In areas where chloroquine-resistant P falciparum is prevalent, atovaquone-proguanil, doxycycline, or mefloquine should be used. In the Thailand-Burma and Thailand-Cambodia border areas where multidrug resistant P falciparum exists, atovaquone-proguanil or doxycycline is preferred.9
In 2000, 27.7 million Americans traveled to areas of the world in which malaria is endemic.11 In 2005, 1528 cases of malaria were reported to the CDC, with 7 deaths reported by the National Malaria Surveillance System.2 Of the 185 reported malaria deaths in the United States from 1963-2001, 57 (46.3%) were in patients who received no chemoprophylaxis. Of those who received chemoprophylactic medications, over a third took medications inappropriate for the area to which they traveled, and another third did not adhere to the prescribing regimen.11
Malaria is largely a preventable illness in travelers if they and their physicians follow a simple approach that involves assessment of malaria risk during travel, avoidance of mosquito bites, adherence to antimalarial drug regimens recommended for the destination, and willingness to seek medical attention urgently should malaria symptoms develop during travel or after the return home. Physicians should consider obtaining malaria smears in the febrile returning traveler.
See end of article for correct answers to questions.
Correct answers: 1. d, 2. c, 3. e, 4. e, 5. d
REFERENCES
- 1.Tong MJ, el-Farra NS, Grew MI. Clinical manifestations of hepatitis A: recent experience in a community teaching hospital. J Infect Dis. 1995;171(suppl 1):S15-S18 [DOI] [PubMed] [Google Scholar]
 - 2.Thewing J, Skarbinski J, Newman RD, et al. Centers for Disease Control and Prevention Malaria surveillance-United States, 2005. MMWR Surveill Summ 2007;56(6):23-38 [PubMed] [Google Scholar]
 - 3.Gubler DJ. Dengue and dengue hemorrhagic fever. Clin Microbiol Rev. 1998;11(3):480-496 [DOI] [PMC free article] [PubMed] [Google Scholar]
 - 4.White NJ. The treatment of malaria. N Engl J Med. 1996;335(11):800-806 [DOI] [PubMed] [Google Scholar]
 - 5.Warrell D, Molyneux M, Beales P. Severe and complicated malaria. Trans R Soc Trop Med Hyg. 1990;84(suppl 2):1-65 [PubMed] [Google Scholar]
 - 6.Mishra SK, Mohapatra S, Mohanty S, Patel NC, Mohapatra DN. Acute renal failure in falciparum malaria. JIACM J Indian Acad Clin Med. 2002;3(2):141-147 [Google Scholar]
 - 7.Griffith KS, Lewis LS, Mali S, Parise ME. Treatment of malaria in the United States: a systematic review. JAMA 2007;297(20):2264-2277 [DOI] [PubMed] [Google Scholar]
 - 8.Murthy GL, Sahay RK, Sreenivas DV, Sundaram C, Shantaram V. Hepatitis in falciparum malaria. Trop Gastroenterol 1998;19(4):152-154 [PubMed] [Google Scholar]
 - 9.Hill D, Ericsson CD, Pearson RD, et al. The practice of travel medicine: guidelines by the Infectious Diseases Society of America. Clin Infect Dis. 2006December15;43(12):1499-1539 Epub 2006 Nov 8 [DOI] [PubMed] [Google Scholar]
 - 10.World Health Organization, Communicable Diseases Cluster Severe falciparum malaria. Trans R Soc Trop Med Hyg. 2000;94(suppl 1):S1-S90 [PubMed] [Google Scholar]
 - 11.Newman RD, Parise ME, Barber AM, Steketee RW. Malaria-related deaths among U.S. travelers, 1963-2001. Ann Intern Med. 2004;141(7):547-555 [DOI] [PubMed] [Google Scholar]